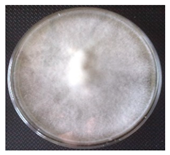
Horticulturae 10 01376 i001
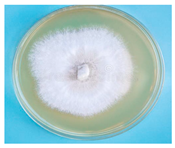
Horticulturae 10 01376 i003
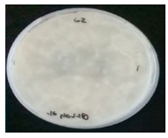
Horticulturae 10 01376 i007
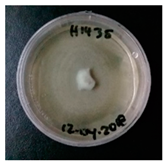
Horticulturae 10 01376 i009
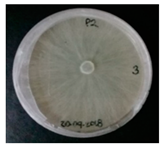
Horticulturae 10 01376 i011

Abstract
This study evaluates the mycoremediation potential of wild mushroom species from Chiapas, Mexico, specifically for high copper concentrations. Nine fungal carpophores were collected from tropical forests near coffee plantations. The morphological characteristics of the fungal strains and fruiting bodies were analyzed. Each specimen was identified through sequencing using the ITS1 and ITS4 primers. The ability to tolerate different concentrations of copper was evaluated by determining the fungal mycelial growth inhibition potential. Copper bioaccumulation by the fungi was quantified using biosorption assays with atomic absorption spectrophotometry. The enzymatic activity of laccase, lignin peroxidase, and manganese peroxidase from the fungal species was also determined in the presence of copper. Phylogenetic analysis identified the fungal species as Agaricus bisporus, A. subrufescens, Calvatia fragilis, Ganoderma coffeatum, G. lucidum, Pleurotus djmor, P. floridanus, Trametes elegans, and T. versicolor, all classified within the Agaromycetes class. The nine fungal species exhibited varying abilities to tolerate Cu2+ concentrations from 30 to 100 mg L−1. At 30 and 60 mg L−1 Cu2+, the G. lucidum H14-35 strain demonstrated the highest biosorption capacity, reaching 76.97%. Overall, the mushrooms in this study showed strong Cu2⁺ tolerance and biosorption, making them promising biomaterials for remediating copper-contaminated soils.
1. Introduction
Agricultural soils have been significantly impacted by the direct disposal of residues and toxic chemical contaminants, which affect their structure and functionality. Soil contamination and degradation can be attributed to anthropogenic activities, including agriculture, industry, and mining [1]. Conventional agriculture, the most prevalent agricultural production model worldwide, heavily relies on chemical fertilizers, pesticides, and various persistent toxic agrochemicals, which have adverse effects on the environment and public health [2]. Among the most persistent contaminants are heavy metals, known for their toxicity, widespread distribution, non-biodegradability, and bioavailability for crop uptake, presenting a significant threat to global food safety and security [3]. Heavy metals are potentially toxic elements that have significantly increased in environmental presence in recent decades due to industrial and agricultural activities [4]. The contamination of agricultural soils by heavy metals, particularly copper, remains a significant global environmental concern. Copper (Cu) is an essential element for plant nutrition, acting as a cofactor in various enzymes and playing crucial roles in photosynthesis, respiration, and the electron transport chain. Additionally, it serves as a structural component of defense genes [5]. However, copper applied to plants at concentrations slightly higher than 30 mg kg−1 of tissue dry weight may induce toxic effects, including growth inhibition in roots and shoots. Similarly, this concentration of copper is considered a toxic contaminant for agricultural soils [6]. Numerous studies have extensively documented the detrimental effects of elevated copper concentrations on various physiological processes in agricultural crops [7,8]. These include inhibition of germination, growth, and photosynthesis, as well as disruptions in essential mineral uptake and chlorophyll biosynthesis [9]. Additionally, copper has been found to adversely affect antioxidant enzyme activities in plants [10].
Coffee cultivation in Chiapas, Mexico, plays a crucial role in the region’s economy and social development, sustaining agricultural communities and livelihoods. Chiapas’ favorable climatic conditions and diverse soil types provide suitable environments for cultivating coffee varieties [11,12]. However, the prevalence of diseases caused by phytopathogenic fungi, particularly coffee rust (Hemileia vastatrix), poses a significant challenge in Chiapas’ coffee-growing regions [13,14]. To combat rust and other fungal diseases, farmers often turn to applying broad-spectrum fungicides, including copper-based compounds like copper oxychloride [15]. The continuous use of copper-based fungicides results in the accumulation of copper residues in coffee agricultural soils, leading to soil contamination. This copper contamination negatively impacts soil health, fertility, and functionality, resulting in reduced crop yields. Additionally, the prolonged and indiscriminate use of fungicides has led to resistance development in the coffee rust pathogen, making fungicides less effective over time [16]. The increasing resistance of coffee rust to fungicides exacerbates the economic and social challenges faced by agricultural communities heavily reliant on coffee cultivation. Addressing copper contamination in coffee agricultural soils and its impact on rust disease needs to focus on sustainable and environmentally friendly alternatives to conventional fungicide use [17].
The adoption of mycoremediation, utilizing native fungi, has gained prominence as an environmentally friendly approach for remediating heavy metal-contaminated soils [18]. Macromycete fungi have emerged as prime candidates due to their robust metal tolerance and accumulation capabilities, particularly relevant in coffee agricultural systems affected by high copper concentrations [19]. At the genetic level, these fungi possess metal-tolerant genes, including copper transporters crucial for sequestering copper ions and mitigating their toxic effects [20]. Basidiomycete’s mycelium protects itself from heavy metals through several mechanisms, including biosorption, extracellular enzyme production (such as laccase and peroxidases), and the synthesis of metallothioneins, which bind and sequester metal ions, thereby reducing their toxicity. These mechanisms are crucial for metal tolerance and detoxification in fungal species. They employ biochemical pathways such as biosorption and intracellular metallothionein production to immobilize and neutralize copper ions within fungal cells [21,22].
Research has established the significant potential of various macromycete fungi in the bioremediation of heavy metals, including copper. For instance, Pleurotus ostreatus has been recognized for its high tolerance and bioaccumulation capabilities in contaminated soils, underscoring its relevance in addressing copper pollution [23]. Similarly, Agaricus bisporus has demonstrated effectiveness in absorbing copper ions from water through ac-cumulation in the mycelium and fruiting bodies [24]. Trametes versicolor has shown promise by sequestering copper ions from aqueous solutions via adsorption and biosorption mechanisms, highlighting its potential for water remediation applications [25]. Furthermore, Ganoderma lucidum’s extracellular enzymes and chelating agents facilitate copper uptake and accumulation from contaminated substrates, suggesting its potential role in soil remediation [26]. These findings underscore the importance of exploring diverse wild macromycete fungi species for their biological potential in the mycoremediation of elevated copper levels. Thus, it is hypothesized that native wild macromycete fungi from soils with high copper concentrations in coffee agroecosystems in Chiapas, Mexico, will exhibit significant potential for mycoremediation, showing varied abilities to tolerate and bioaccumulate copper, and thus provide effective solutions for mitigating copper contamination in agricultural soils. In this study, we aim to investigate such fungi from soils with high copper concentrations in coffee agroecosystems in Chiapas, Mexico, to evaluate their potential for effective mycoremediation.
2. Materials and Methods
2.1. Study Area
Specimens of macromycete fungi were collected during the summer season (July 2022) from coffee plantations located in Ocuilapa de Juárez (16°51′05.4″ N, 93°25′29.5″ W, altitude: 820 masl) in the municipality of Ocozocoautla de Espinosa, Chiapas, Mexico (Figure 1). The soils in the area are of the vertisol type, dark brown in color, shallow, and with good moisture content. The region experiences an average annual precipitation of 1000 to 1200 mm and an average temperature of 22 °C. The vegetation mainly consists of sub-perenifolium tropical forest, with occasional fragments of perennifolia tropical forest and montane mesophilic forest.
Figure 1.
Location of the study site and macromycete fungi collection.
2.2. Physicochemical Soil Analysis
Soil samples were collected at a depth of 0–20 cm at three different points of the coffee plantation for physicochemical analysis. Soil texture was determined by the hydrometer method [27]. The pH and electric conductivity (EC) were measured by using a digital pH meter, a Mettler® Toledo (Ohio, EE.UU), in a 1:10 (weight/volume) aqueous solution. The cation exchange capacity (CEC) was determined according to the Official Mexican Standard NOM-021-SEMARNAT-2000 (https://www.dof.gob.mx/nota_detalle.php?codigo=717582&fecha=31/12/2002#gsc.tab=0 (accessed on 19 December 2024)). The determination of total nitrogen and total carbon was carried out using a FLASH 2000® auto-analyzer (Thermoscientific™, Massachusetts, EE.UU. The determination of total phosphorus was conducted with the solubilization method of HNO3/HClO4 [28]. The content of K and Ca was measured using atomic emission spectrometry, while the content of Mg and Cu was determined by flame atomic absorption spectrometry [29]. All determinations were performed in triplicate.
2.3. Mushroom Sampling
The fruiting bodies, or carpophores, of macromycete fungi growing in the soil or on tree trunks within the coffee plantations were carefully collected according to the recommendations provided in ref. [30]. The minimum area method was utilized to assess the species richness within the agricultural ecosystem and to estimate the necessary number of specimens to be collected [31]. During sampling, meticulous attention was given to ensure that the fruiting bodies were intact, fully developed, and free from any signs of insect, snail, or mold infestations. Technical data sheets were created to record the collection details and key morphological characteristics of the fungi, adhering to the guidelines suggested by Guzman [32]. Taxonomic identification of the fungal species was verified using the MycoBank database (http://www.mycobank.org, accessed on 22 August 2023).
2.4. Isolation and Culture of Native Mushroom
The fruiting bodies of each macromycete were aseptically dissected using a sterilized scalpel within a laminar flow hood. Fruit body fragments approximately 1 cm2 in size were placed into Petri dishes and disinfected with a 3% sodium hypochlorite solution for 3 min. Following disinfection, the tissues were thoroughly rinsed with sterile distilled water to eliminate any residual chlorine. The disinfected tissues were then immersed in 70% ethanol for 5 min, followed by a final rinse with sterile distilled water for 2 min. Two sections of disinfected carpophores from each fungus were subsequently cultured on specific media: potato dextrose agar (PDA), prepared with 200 g of potato flour, 20 g of dextrose, and 15 g of agar per liter and adjusted to a pH of 6.8; and malt extract agar (MEA), containing 12.7 g of malt extract, 2.7 g of dextrin, 2.3 g of glycerin, 0.7 g of casein peptone, and 15 g of agar per liter and also adjusted to a pH of 6.8. The plates were incubated at 25 °C for 5 days. Plates exhibiting full coverage with fungal mycelium were considered positive isolations. Fungal strains were preserved in test tubes with 70% glycerol at 4 °C, while additional pure cultures were maintained at 8 °C for further testing.
2.5. Molecular Identification of Native Mushrooms
DNA was extracted from the mycelium using the method outlined by Dellaporta et al. [33]. The quality of the extracted DNA was verified through agarose gel electrophoresis in 1X TAE buffer, and DNA fragments were visualized using a UV-transilluminator UPV-3000® (Massachusetts, EE.UU). The amplification of the internal transcribed spacer (ITS) region was carried out through polymerase chain reaction (PCR) using the primers ITS1 (TCC GTA GGT GAA CCT GCG G) and ITS4 (TCC TCC GCT TAT TGA TAT GC) [34]. The PCR was performed in a thermocycler (BIORAD®, Hercules, California, USA) with the following program: initial denaturation at 95 °C for 2 min, followed by 35 cycles of denaturation at 95 °C for 30 s, annealing at 55 °C for 30 s, extension at 72 °C for 1 min, and a final extension step at 72 °C for 10 min. After PCR amplification, 0.8% agarose gel electrophoresis was conducted to verify the quality of the resulting PCR products. The PCR products were subsequently sequenced at Macrogen® (Seoul, Republic of Korea) using the Sanger sequencing. The acquired sequences in fasta format underwent alignment and analysis using CLUSTAL X software (v. 2.0), with minor modifications conducted through the utilization of the BIOEDIT editor (v. 7.2.5) [35]. Following this, a comparison was conducted with other reference sequences obtained via a BLAST search in GenBank (www.ncbi.nlm.nih.gov/, accessed on 20 December 2024).
2.6. Potential Inhibition of Macromycete Fungal Mycelium by Copper
This study investigated the potential inhibition of macromycete fungal mycelium by copper over a period of 6 to 12 days. The percentage of mycelial growth inhibition was evaluated to determine the effect of copper on macromycete fungi. Malt extract agar (MEA) was the chosen culture medium, with copper sulfate pentahydrate (CuSO4·5H2O) at concentrations of 30, 60, and 100 mg L−1, adjusting the pH to 6.0. The commercial fungicide Oxicob 85®, Basel, Switzerland (containing copper oxychloride at 100 mg L−1) was used as a positive control. Petri dishes were inoculated with 1.0 cm2 mycelium-colonized fragments, and daily measurements of mycelial growth diameter (cm) were recorded over time (days). Each concentration was evaluated in four replicates for each fungus, and the percentage of inhibition (%) [36] was calculated with Equation (1):
where, Ct means the mycelial growth diameter on MEA medium without metal (control), and Ca is the mycelial growth diameter on MEA medium supplemented with copper (Cu2+).
Additionally, the growth kinetics of the fungal mycelium from each macromycete fungus were evaluated at the various copper concentrations mentioned above.
2.7. Copper Biosorption Assay Using Native Mushrooms
The copper biosorption experiments were conducted using 250 mL Erlenmeyer flasks containing 60 mL of liquid malt extract medium (12.75 g·L−1 malt extract, 2.75 g·L−1 dextrin, 2.35 g·L−1 glycerin, and 0.78 g·L−1 peptone of casein), supplemented with copper sulfate (CuSO4·5H2O) at concentrations of 30, 60, and 100 mg L−1. Each flask was inoculated with three 10 mm diameter discs of medium colonized by the mycelium of each fungal strain and incubated at 25 °C with continuous agitation for 12 days. After incubation at 150 rpm, the fungal biomass from the liquid medium was separated by filtration, washed with distilled water five times, and dried at 37 °C until a constant weight was achieved. The supernatant was retained for copper concentration analysis. A control experiment without copper was conducted under identical conditions. Copper biosorpted per gram of biomass (q) and biosorption efficiency (E) were calculated using Equations (2) and (3) detailed by Kan et al. [37]:
where Ci and Cf represent the initial and final metal ion concentrations (mg·L−1), respectively, m indicates the dried mass (fungal mycelium) of the biosorbent in grams, and V denotes the reaction volume in milliliters.
The copper adsorption capacity of the mushrooms was determined using flame atomic absorption spectrometry (VARIAN, SpectrAA 220, California, EE.UU) at a wavelength (λ) of 324.8 nm. Fungal samples were centrifuged at 4000 rpm for 10 min, followed by acid digestion via microwave digestion (CEM brand, Mars 6) using 70% nitric acid (Merck®, Darmstadt, Germany). The spectrometer was calibrated according to the manufacturer’s guidelines, using calibration and control standards, with a calibration curve prepared from a 1000 mg L−1 copper (Cu2+) standard ranging from 0 to 120 mg L−1. The gas mixture comprised air/acetylene with airflow rates of 3.5 L·min−1 and 1.5 L·min−1, respectively. Control experiments were conducted without fungal biomass. Copper concentrations adsorbed by the fungi were quantified in mg·L−1.
2.8. Enzyme Activity Assay
The cultures were grown on PDA for 10 days at 25 °C. After this, three 1 × 1 cm2 plugs were cut and added into Erlenmeyer flasks containing 60 mL of potato dextrose broth. CuSO4·5H2O was used at three different concentrations (30, 60, and 100 mg L−1). A flask for each strain without any inducer was used as the control (0 mg L−1). The flasks were incubated in a shaker (150 rpm, 25 °C), and the samples were measured daily for a total of 12 days. The supernatant was separated from the mycelium by centrifugation (10,000 rpm, 4 °C, 5 min), and enzyme activities were determined following the methodology recommended by Vršanská et al. [38].
2.8.1. Laccase Activity
The laccase activity was measured at 415 nm by detecting the oxidation of 10 m MABTS (2, 2-azinobis (3-ethylbenzothiazoline-6-sulfonate), Sigma Aldrich, Massachusetts, EE.UU) at pH 4.5 in 0.1 M sodium acetate buffer.
2.8.2. Lignin Peroxidase Activity
The LiP activity was determined by the formation of veratraldehyde from 25 mM veratryl alcohol (Sigma Aldrich, Massachusetts, EE.UU) in 100 mM tartrate buffer (pH 3.0). The reaction started with the addition of hydrogen peroxide (54 mM), and the appearance of veratraldehyde was determined at 310 nm.
2.8.3. Manganese-Dependent Peroxidase Activity
The MnP activity was measured by 20 mM dimethylsulfoxide (DMP, Sigma Aldrich, Massachusetts, EE.UU) oxidation method in 65.8 mM malonate buffer (pH 4.5) at 469 nm. The enzyme activities were determined spectrophotometrically using a UV/VIS Lambda 25 Spectrophotometer (Perkin-Elmer, Massachusetts, EE.UU). One unit of the enzyme activity was defined as 1 µM of substrate oxidized per minute under the assay conditions.
2.9. Statistical Analysis
The data from the experimental tests were analyzed using a one-way analysis of variance (ANOVA) at a significance level of α = 0.05, conducted with Statgraphics Centurion XV.2 statistical software (The Plains, VA, USA). Prior to the ANOVA, the homogeneity of variances was verified using Levene’s test to ensure the assumption of equal variances. Tukey’s honest significant difference (HSD) test (p < 0.05) was applied for post-hoc mean comparisons. Enzyme activity assays were performed in triplicate, and the results were expressed as the mean ± standard deviation. If the assumption of homogeneity was not met, appropriate data transformations were applied to meet the requirements for ANOVA.
3. Results
3.1. Physical–Chemical Characteristics of the Soil
According to the Official Mexican Standard NOM-021-SEMARNAT-2000, the soil samples exhibited significant variations (p < 0.05) in the physicochemical parameters studied (Table 1). The samples had a clayey texture, with pH values ranging from 5.8 to 6.4, indicating slightly acidic to neutral conditions. Electrical conductivity (EC) ranged from 0.21 to 0.53 dS·m−1, suggesting that the soils are saline or slightly saline. The cation exchange capacity (CEC) was highest at site S2, which is favorable for soil fertility. Soil organic matter (SOM) content ranged from 8.09% to 9.09%, which is high and advantageous. Total nitrogen (N) content was low at all sites. Total phosphorus (P) content was within the optimal range. Total potassium (K) content ranged from 0.34% to 0.52%, which is adequate. Calcium (Ca) content varied from 621.8 to 793.2 mg·kg−1, which is normal. Copper (Cu) content was elevated at site S1 compared to sites S2 and S3, and magnesium (Mg) content showed no significant differences among the sites.
Table 1.
The physicochemical characteristics of the coffee plantation soils.
3.2. Taxonomic Identification of Native Macromycete Fungi
Nine different strains of macromycete fungi were collected from coffee plantations. The morphological characteristics of native fungi are presented in Table 2.
Table 2.
Morphological characteristics, fungal mycelium, and fruiting bodies of native fungi collected in coffee plantations.
These fungi were classified into the Basidiomycota division, Agaricomycetes class, and Agaricales order. Based on intergenic spacer (ITS) amplification, the macromycete fungi were grouped into five taxonomic genera: Agaricus, Calvatia, Ganoderma, Pleurotus, and Trametes (Table 3). Strain 830, isolated from site S1, exhibited 100% genetic similarity with an Agaricus subrufescens strain (KY114572.1), while strain 831, obtained from site S3, showed 100% identity with an Agaricus bisporus strain (KM677957.1). Strain Lyc3, isolated from site S1, displayed 99.3% similarity with a Calvatia fragilis strain (AJ486957.1). Strains G2 and H14-35 were classified under the Ganoderma genus and showed genetic similarity with Ganoderma coffeatum (KU315204.1) and Ganoderma lucidum (MG706230.1), respectively. Strains P2 and Psc exhibited 99.8% similarity with Pleurotus djamor (KX573922.1) and Pleurotus floridanus (KX836221.1), respectively. Two strains were grouped under the Trametes genus. Strain TE, isolated from site S1, was similar to Trametes elegans (JN164921.1) with a 99.5% genetic identity, while strain H14-48, obtained from site S3, had a 99.7% genetic identity with Trametes versicolor (KC176306.1).
Table 3.
Molecular and taxonomic characteristics of native macromycete.
3.3. Effect of Copper on the Growth Inhibition of Macromycete Fungal Mycelium
The macromycete fungi exhibited varying degrees of mycelial inhibition when exposed to different concentrations of copper (Figure 2). As the copper concentration increased from 30 to 100 mg L−1, the percentage of mycelial inhibition also increased significantly (p < 0.05). Notably, at 30 mg L−1 copper, most fungi tolerated the presence of copper in the culture medium, while strains Ganoderma lucidum H14-35 and Agaricus bisporus 831 exhibited notable levels of mycelial inhibition. Upon exposure to 60 mg L−1 copper, the percentage of mycelial inhibition increased significantly (p < 0.05), with G. lucidum H14-35 showing a particularly high inhibition percentage, exceeding 80.0%, while Trametes elegans TE and Agaricus subrufescens 830 displayed lower levels of inhibition. At 100 mg L−1 copper, the majority of fungi exhibited inhibition percentages above 85%. Interestingly, T. elegans TE consistently exhibited the lowest percentage of inhibition across all tested copper concentrations. Additionally, the positive control (Oxicob 85® fungicide), added at a concentration of 100 mg L−1 copper, inhibited the mycelial growth of most fungi within a range of 30 to 60%. These findings underscore the varying responses of macrofungi to copper exposure and provide valuable insights into their ability to tolerate and respond to environmental stressors.
Figure 2.
The percentage of fungal mycelial growth inhibition by different copper concentrations. Mean values of three replicates. Means followed by the same letter are non-significantly different (Tukey test, p < 0.05).
Additionally, the growth kinetics of fungal mycelium from each macrofungus were assessed at various copper concentrations, as detailed earlier (see Supplementary Materials Figure S1). In Figure S1A,B, the mycelial growth of strains Ganoderma lucidum H14-35 and G. coffeatum G2, respectively, is depicted. Both strains exhibited rapid growth, reaching a mycelial diameter greater than 6.0 cm within six days in the absence of copper. However, upon the addition of copper to the culture medium (30, 60, or 100 mg L−1), a significant decrease in mycelial growth was observed. Strain Trametes versicolor H14-48 (Figure S1C) displayed slow mycelial growth (less than 4 cm) regardless of copper presence in the culture medium. Trametes elegans TE (Figure S1D) exhibited notable behavior when grown in the presence of copper, reaching a mycelial diameter of 9.0 cm after six days in a culture medium containing 100 mg L−1 copper, confirming its copper tolerance. Strains Pleurotus floridanus PsC (Figure S1E) and P. djamor P2 (Figure S1F) showed mycelial growth potential in the presence of 30 mg L−1 copper, but as the copper concentration increased, mycelial diameter decreased significantly (p < 0.05). Agaricus species also demonstrated the ability to grow in the presence of copper. Strain Agaricus subrufescens 830 (Figure S1G) stood out for its growth in the presence of 100 mg L−1 copper and chemical fungicide, reaching a mycelial diameter above 8 cm after six days. Strain Calvatia fragilis LyC3 exhibited low growth potential in the presence of copper, with a maximum mycelial diameter not exceeding 2.5 cm. Notably, only strains T. elegans TE and A. subrufescens 830 showed the ability to grow in the presence of the chemical fungicide applied at a concentration of 100 mg L−1.
3.4. Copper Biosorption Efficiency by Native Macromycete Fungi
This study evaluated the copper biosorption potential and efficiency of nine native macroscopic fungi across three concentrations (30, 60, and 100 mg L−1) (Table 4). Ganoderma lucidum H14-35 demonstrated notable biosorption capabilities, achieving the highest copper biosorption mycelial at 30 mg L−1 (q = 23.0 mg L−1), with an efficiency (E) of 77.0%. In contrast, Ganoderma coffeatum G2 exhibited lower biosorption capacities, ranging from 0.8 mg L−1 at 30 mg L−1 to 4.5 mg L−1 at 100 mg L−1, corresponding to efficiencies between 3.0% and 5.0%. Trametes versicolor H14-48 consistently exhibited effective biosorption across all concentrations, reaching 11.1 mg L−1 at 30 mg L−1 and maintaining efficiencies above 7.0% even at 100 mg L−1. Trametes elegans TE displayed variable biosorption rates, with significant uptake observed at 100 mg L−1 (11.8 mg L−1), indicating adaptability to higher copper concentrations. Pleurotus floridanus Psc and P. djamor P2 demonstrated moderate to high biosorption capacities, particularly notable at 30 mg L−1. Agaricus subrufescens 830 and A. bisporus 831 exhibited distinct biosorption abilities, with A. bisporus 831 demonstrating superior performance at lower concentrations. Calvatia fragilis Lyc3 consistently exhibited modest biosorption rates across all concentrations, albeit generally lower compared to other strains. The submerged biomass of these fungi varied, with G. lucidum H14-35 showing 2.16 g at 30 mg L−1, while T. elegans TE exhibited the highest submerged biomass (2.85 g) at 30 mg L−1. P. floridanus Psc had the highest submerged biomass, 3.05 g at 30 mg L−1, whereas C. fragilis Lyc3 showed a relatively low submerged biomass of 2.42 g at 30 mg L−1.
Table 4.
Copper biosorption efficiency by native macromycete fungi.
3.5. Lac, LiP, and MnP Enzymatic Activities of Native Macromycete Fungi
Variations were observed in the enzymatic activities of laccase (Lac), lignin peroxidase (LiP), and manganese peroxidase (MnP) across various native macromycete fungi cultivated for 12 days under different copper concentrations (Table 5).
Table 5.
Enzymatic activities of laccase (Lac), lignin peroxidase (LiP), and manganese peroxidase (MnP) in native macromycete fungi cultivated for 12 days under varying copper concentrations.
A key observation is the consistent increase in laccase activity with rising copper levels, particularly in strains such as Pleurotus floridanus Psc and Ganoderma lucidum H14-35. Strain Psc exhibited the highest laccase activity at all copper concentrations, highlighting copper’s role as a potent inducer for this enzyme. Laccase activity in strains G. coffeatum G2 and Calvatia fragilis Lyc3 also showed considerable elevation, with peak values at moderate copper levels (60 mg L−1), further emphasizing the enzyme’s responsiveness to copper induction. In contrast, strain 830 exhibited more moderate laccase activity, particularly at the highest copper concentration (100 mg L−1), where a slight decline in activity was observed.
For lignin peroxidase (LiP), although the overall activity was lower compared to laccase, important findings were noted. Strains G2 and Psc showed substantial increases in LiP activity at the highest copper concentration (100 mg L−1), with G2 demonstrating one of the highest LiP activities overall. This suggests that these strains are particularly efficient in lignin degradation under copper-induced conditions, making them promising candidates for biotechnological applications such as lignocellulosic biomass degradation and environmental bioremediation. Lyc3 and Pleurotus djamor P2 also exhibited moderate to strong LiP activities, particularly at 60 and 100 mg L−1, supporting the idea that copper serves as a stimulant for LiP production in these strains. Interestingly, strain Agaricus bisporus 831 displayed relatively stable but low LiP activity across all copper concentrations, indicating that LiP production in this strain is less sensitive to copper compared to others. Manganese peroxidase (MnP) activity, while generally low across the strains, showed notable increases in specific fungi, particularly in Psc and Trametes versicolor H14-48, at higher copper concentrations. Although MnP was not as significantly induced by copper as laccase, its role in oxidative processes in these fungi under copper stress remains relevant. The highest MnP activity was recorded in strain Psc at 100 mg L−1, indicating that this strain not only excels in laccase production but also upregulates MnP under copper stress.
4. Discussion
This study assessed the potential of wild strains for mycoremediation in copper-contaminated coffee soils. Significant variations were observed in the physicochemical properties of the soil samples. The clayey texture and slightly acidic to neutral pH are conducive to coffee cultivation, consistent with findings that slightly acidic soils optimize coffee growth [39]. This pH range enhances nutrient availability and microbial activity, which is essential for coffee plant health. Furthermore, the EC indicates salinity levels manageable for most coffee crops, preventing the adverse effects of high salinity [40]. The CEC signifies good nutrient retention, which is crucial for soil fertility and healthy coffee plants [41]. High soil organic matter content aligns with findings that rich organic matter improves soil structure and nutrient availability, thereby enhancing soil fertility and plant growth [42]. Adequate levels of total nitrogen and phosphorus are vital for coffee productivity, underscoring their importance in photosynthesis and plant development [43]. Potassium content supports plant health and soil fertility, while calcium and magnesium levels indicate well-supplied soils, enhancing nutrient availability and promoting healthy plant growth [44]. However, elevated copper levels, particularly at some sites, could induce toxicity. High copper levels are known to adversely affect plant growth and photosynthesis, consistent with studies on copper’s toxic effects [45].
The morphological characterization of the macromycete fungi revealed distinct and diverse features across strains, emphasizing their taxonomic uniqueness and ecological adaptability. Species of Agaricus, Calvatia, Ganoderma, Pleurotus, and Trametes exhibited unique morphological traits that suggest their potential for survival and adaptation in copper-contaminated coffee plantation soils (Table 2). These traits are crucial for their ecological roles and potential applications in bioremediation. The robust structure and mycelial texture of Ganoderma species indicate their ability to thrive in harsh environments [46], while the fibrous and velvety mycelial textures of Pleurotus and Trametes species suggest efficient substrate colonization and nutrient absorption [47,48]. These adaptations to copper-contaminated soils likely reflect evolved mechanisms for heavy metal tolerance and detoxification, positioning these fungi as promising candidates for mycoremediation efforts. Therefore, these wood-decay fungi possess significant potential for soil remediation, especially when applied in controlled forms such as mushroom sticks. These mushroom sticks, which consist of mycelium and substrate, can be buried in contaminated soils. Once buried, the fungi colonize the area, breaking down organic matter and contributing to the improvement of soil structure and health. This approach may enhance the fungi’s ability to degrade contaminants, sequester heavy metals like copper, and improve soil fertility.
The taxonomic identification of native macromycete fungi revealed significant genetic diversity among the isolates. Based on intergenic spacer (ITS) amplification, the fungi were classified into five genera: Agaricus, Calvatia, Ganoderma, Pleurotus, and Trametes. Strains 830 and 831, identified as Agaricus subrufescens and A. bisporus, demonstrate potential for soil remediation through copper bioaccumulation facilitated by intracellular metallothioneins and extracellular polysaccharides [49]. Strain Lyc3, showing 99.3% similarity to Calvatia fragilis, likely sequesters copper via oxalates, which chelate metal ions and immobilize them in the soil. Strains G2 and H14-35, identified as Ganoderma coffeatum and G. lucidum, are particularly effective in bioremediation, with G. lucidum known to produce laccase and manganese peroxidase, enzymes that oxidize and detoxify copper, while enhancing sequestration through exopolysaccharides [50]. Pleurotus strains P2 and Psc, identified as Pleurotus djamor and P. floridanus, excel in lignocellulosic degradation, aided by laccase and peroxidases, which facilitate copper adsorption and immobilization in fungal biomass [21]. The Trametes genus, including strains TE and H14-48, is notable for the bioremediation of copper-contaminated water, driven by its enzymatic ability to degrade complex pollutants [51]. These fungi exhibit distinct biochemical mechanisms for copper detoxification, positioning them as valuable tools for mycoremediation strategies in contaminated environments.
The three species commonly found in forest leaf litter (Agaricus bisporus, A. subrufescens, and Calvatia fragilis), as well as the wood-decay fungi (e.g., Ganoderma, Trametes, and Pleurotus), exhibit promising potential for copper bioremediation in contaminated soils. These fungi employ several biochemical mechanisms for copper biosorption, including the production of extracellular enzymes such as laccases and peroxidases, which facilitate the oxidation and chelation of copper ions. Additionally, these fungi produce metal-binding proteins like metallothioneins that bind copper, immobilizing it and preventing its uptake by plants. Their lignocellulolytic activity further aids in the sequestration of copper by breaking down organic matter, which helps to trap the metal in the fungal biomass. These combined mechanisms make wood-decay fungi particularly efficient in detoxifying copper from polluted environments.
The varying degrees of mycelial inhibition observed in macromycete fungi exposed to increasing concentrations of copper highlight their differential tolerance to this heavy metal, which is crucial for their potential application in bioremediation. In addition to the production of metallothioneins, the fungi in this study also employ enzymes such as laccases and peroxidases, which are crucial for copper detoxification. Laccases are copper-dependent enzymes that oxidize phenolic compounds and facilitate copper sequestration, while peroxidases contribute by breaking down lignocellulosic materials, further aiding in copper immobilization. These enzymes work together with other metal-binding proteins, enhancing the fungi’s ability to detoxify copper and preventing its toxic effects on plant systems. Their combined activity not only supports the degradation of lignocellulosic materials but also serves to sequester and immobilize copper, contributing to the overall bioremediation process. As copper concentrations increased from 30 to 100 mg L−1, a clear dose-dependent toxic effect was evident, with significant mycelial inhibition. Notably, G. lucidum H14-35 and A. bisporus 831 displayed higher sensitivity even at lower copper concentrations, suggesting a limited capacity to tolerate and detoxify copper. This heightened sensitivity can be attributed to the disruption of essential physiological processes and enzyme activities involved in fungal growth and metabolism, as noted by Priyanka et al. [52]. In contrast, T. elegans TE exhibited the lowest inhibition across all concentrations, indicating strong copper tolerance. This resilience may be due to efficient mechanisms for copper sequestration and detoxification, such as the production of metallothioneins and other metal-binding proteins, which mitigate copper toxicity, as reported by Baldrian et al. [53]. Additionally, T. elegans TE’s ability to grow in the presence of 100 mg L−1 copper and the Oxicob 85® fungicide underscores its potential for bioremediation in highly contaminated environments.
Growth kinetics assessments revealed that Ganoderma strains, which initially grew rapidly in the absence of copper, experienced significant growth reduction upon copper exposure, indicating susceptibility to copper-induced stress. Conversely, T. versicolor exhibited consistently slow growth, regardless of Cu concentration, suggesting a different physiological adaptation. T. elegans TE demonstrated exceptional growth even at 100 mg L−1 copper, likely due to its efficient oxidative stress response mechanisms, as discussed by Kostadinova et al. [54]. Pleurotus species showed reduced growth with increasing copper concentrations, indicating moderate sensitivity, possibly due to limited expression of detoxification pathways. Meanwhile, A. subrufescens 830 showed significant growth under high copper and fungicide conditions, suggesting a unique adaptation involving enhanced antioxidant defenses and efficient metal efflux systems. The resilience of T. elegans TE and A. subrufescens 830 to both copper and chemical fungicides highlights their dual potential for remediating environments contaminated with heavy metals and agrochemicals. These differential tolerance levels suggest that species like T. elegans TE may be particularly effective in remediating copper-contaminated soils. Understanding the molecular and biochemical pathways that confer this tolerance will enhance their field application, promoting soil health and sustainability in agricultural regions, as noted by recent studies [53,54].
The evaluation of copper biosorption efficiency among native macroscopic fungi revealed significant variability, highlighting their potential for environmental remediation. Ganoderma lucidum H14-35 demonstrated exceptional biosorption at 30 mg L−1, with an efficiency of 77.0%. This high efficiency is likely due to robust cellular mechanisms for metal uptake and sequestration, possibly involving active transport systems and intra-cellular binding proteins, as suggested by recent studies on fungal biosorption [50]. In contrast, G. coffeatum G2 exhibited much lower biosorption across all concentrations, indicating a limited capacity to sequester copper effectively. This variation within the Ganoderma genus underscores the strain-specific differences in biosorption efficiency. Trametes versicolor H14-48 consistently maintained effective biosorption across all copper concentrations, with efficiencies exceeding 7.0% at 100 mg L−1. Its strong adaptability to copper stress likely arises from an efficient expression of metal-binding proteins and extracellular polysaccharides that facilitate metal ion adsorption, as reported by Rau et al. [55].
Similarly, T. elegans TE showed significant uptake at 100 mg L−1, indicating its potential for high-concentration remediation applications. This adaptability to higher copper levels may be attributed to robust oxidative stress response and enhanced metal detoxification pathways. Pleurotus floridanus Psc and P. djamor P2 exhibited moderate to high biosorption capacities, particularly at 30 mg L−1, aligning with their lignocellulosic degradation capabilities, which likely aid in heavy metal sequestration [47]. Agaricus subrufescens 830 and A. bisporus 831 demonstrated distinct biosorption abilities, with A. bisporus 831 performing better at lower concentrations, suggesting more efficient copper uptake mechanisms at reduced exposure levels, possibly involving high-affinity transport systems [49]. Calvatia fragilis Lyc3 exhibited modest biosorption rates across all concentrations, which, although lower than other strains, still suggests potential for remediation, particularly in environments with lower copper contamination. These findings emphasize the importance of selecting specific strains for targeted bioremediation applications. The differential biosorption efficiencies observed suggest that strains like G. lucidum H14-35 and T. versicolor H14-48 may be particularly effective in mitigating copper contamination across various environmental settings [50,51].
In relation to the enzymatic activities observed, Pleurotus floridanus Psc and Ganoderma lucidum H14-35 exhibited the highest laccase activities, highlighting copper’s role as a potent inducer of laccase production. This strong laccase activity can be attributed to copper’s involvement as a cofactor, enhancing enzyme catalysis and promoting the oxidation of phenolic compounds, crucial for lignin degradation and detoxification [56]. The ability of G. coffeatum G2 and Calvatia fragilis Lyc3 to reach peak laccase activity at moderate copper concentrations (60 mg L−1) emphasizes their capacity to use copper in activating oxidative enzymes, potentially through the upregulated expression of copper-binding proteins, which stabilize enzyme structure and function [52]. For lignin peroxidase (LiP), the high activity observed in G. coffeatum G2 and P. floridanus Psc, particularly at 100 mg L−1, suggests copper-induced activation of oxidative stress response mechanisms. These fungi likely produce LiP to cope with oxidative stress by breaking down complex lignin structures and detoxifying reactive oxygen species [57]. The elevated LiP production under copper exposure aligns with findings suggesting efficient electron transfer systems in these strains, where copper facilitates redox cycling [58]. In contrast, the stable but low LiP activity in Agaricus bisporus 831 indicates reduced responsiveness to copper, potentially due to lower regulation of peroxidase genes in this species [57]. MnP activity, although generally lower than laccase, increased significantly in Pleurotus floridanus Psc and Trametes versicolor H14-48 at higher copper concentrations. This suggests that MnP plays a key role in mitigating copper-induced oxidative stress by catalyzing the oxidation of Mn2⁺ to Mn3⁺, which can oxidize phenolic compounds and contribute to lignin degradation [58]. The combined upregulation of laccase and MnP in P. floridanus Psc likely reflects a dual biochemical strategy for detoxifying copper and breaking down lignin, making this strain highly effective for bioremediation in copper-contaminated environments.
5. Conclusions
This study demonstrates the significant potential of native macromycete fungi for mycoremediation of copper-contaminated soils in coffee plantations, particularly in Chiapas, Mexico. The diverse physicochemical properties of the soil and the varied responses of fungal strains to copper exposure underscore the importance of selecting specific fungi for effective bioremediation. Ganoderma lucidum H14-35 and Trametes versicolor H14-48 exhibited notable copper biosorption capabilities, while T. elegans TE showed exceptional tolerance to high copper concentrations, suggesting their suitability for remediating heavily contaminated environments. The genetic diversity among the fungal isolates highlights their adaptability and potential for environmental applications. Furthermore, strains such as P. floridanus Psc and A. subrufescens 830 demonstrated efficient biomass production even under copper stress, indicating robust copper sequestration mechanisms. These findings emphasize the need for targeted selection of fungal strains to optimize bioremediation strategies, enhancing soil health and agricultural sustainability.
Supplementary Materials
The following supporting information can be downloaded at https://www.mdpi.com/article/10.3390/horticulturae10121376/s1. Figure S1: Growth kinetics of fungal mycelium from each macromycete cultivated at different copper concentrations.
Author Contributions
Laboratory experiments, A.C.D.L.C., V.M.R.-V., and C.I.R.-M.; analytical and genetic tools, L.A.M.-G., E.G.-R., and A.G.-J.; investigation, A.G.-J. and C.I.R.-M.; resources, E.G.-R. and J.J.V.-M.; data analysis, C.I.R.-M., L.A.M.-G., F.A.R.-M. and R.R.-R.; writing of the manuscript, C.I.R.-M., L.A.M.-G., and R.R.-R. All authors have read and agreed to the published version of the manuscript.
Funding
This research was funded by Tecnológico Nacional de México No. 19337.24-P and 19414.24-P.
Data Availability Statement
The authors declare that all relevant data supporting the findings of this study are included in this article.
Acknowledgments
We thank CONAHCyT for the scholarship awarded to Areli Castellanos De La Cruz to pursue master’s studies and for the support to Clara Ivette Rincón Molina for conducting postdoctoral research. We also thank Miguel Angel Gómez Jiménez for assistance in the collection and identification of macromycete fungi.
Conflicts of Interest
The authors declare no conflicts of interest.
References
- Borrelli, P.; Robinson, D.A.; Fleischer, L.R.; Lugato, E.; Ballabio, C.; Alewell, C.; Meusburger, K.; Modugno, S.; Schütt, B.; Ferro, V.; et al. An assessment of the global impact of 21st century land use change on soil erosion. Nat. Commun. 2017, 8, 2013. [Google Scholar] [CrossRef] [PubMed]
- Sumberg, J.; Giller, K.E. What is ‘conventional’ agriculture? Glob. Food Sec. 2022, 32, 100617. [Google Scholar] [CrossRef]
- Rodríguez, L.; Ruiz, E.; Alonso-Azcárate, J.; Rincón, J. Heavy metal distribution and chemical speciation in tailings and soils around a Pb-Zn mine in Spain. J. Environ. Manag. 2009, 90, 1106–1116. [Google Scholar] [CrossRef] [PubMed]
- Briffa, J.; Sinagra, E.; Blundell, R. Heavy metal pollution in the environment and their toxicological effects on humans. Heliyon 2020, 6, e04691. [Google Scholar] [CrossRef]
- Mir, A.R.; Pichtel, J.; Hayat, S. Copper: Uptake, toxicity and tolerance in plants and management of Cu-contaminated soil. Biometals 2021, 34, 737–759. [Google Scholar] [CrossRef]
- Zhang, H.; Sun, Y.; Wu, X.; Wang, L. Effect of Copper Toxicity on Root Morphology, Ultrastructure, and Copper Accumulation in Moso Bamboo (Phyllostachys pubescens). Z. Für Naturforschung C 2010, 69, 399–406. [Google Scholar] [CrossRef]
- Kumar, V.; Pandita, S.; Singh, S.G.P.; Sharma, A.; Khanna, K.K.P.; Bali, A.S.; Setia, R. Copper bioavailability, uptake, toxicity and tolerance in plants: A comprehensive review. Chemosphere 2021, 262, 127810. [Google Scholar] [CrossRef]
- Ahsan, N.; Lee, D.G.; Lee, S.H.; Kang, K.Y.; Lee, J.J.; Kim, P.J.; Yoon, H.S.; Kim, J.S.; Lee, B.H. Excess copper induced physiological and proteomic changes in germinating rice seeds. Chemosphere 2007, 67, 1182–1193. [Google Scholar] [CrossRef] [PubMed]
- Adrees, M.; Ali, S.; Rizwan, M.; Ibrahim, M.; Abbas, F.; Farid, M.; Zia-ur-Rehman, M.; Irshad, M.; Bharwana, S.A. The effect of excess copper on growth and physiology of important food crops: A review. Environ. Sci. Pollut. Res. 2015, 22, 8148–8162. [Google Scholar] [CrossRef]
- Shaw, P.D.; Dixon, R.A.; Lamb, C.J. Copper-induced growth inhibition, oxidative stress and ultrastructural alterations in freshly grown water lettuce (Pistia stratiotes L.). Comptes Rendus Biol. 2000, 332, 623–632. [Google Scholar] [CrossRef]
- Schroth, G.; Laderach, P.; Dempewolf, J.; Philpott, S.; Haggar, J.; Eakin, H.; Castillejos, T.; Garcia Moreno, J.; Soto Pinto, L.; Hernandez, R.; et al. Towards a climate change adaptation strategy for coffee communities and ecosystems in the Sierra Madre de Chiapas, Mexico. Mitig. Adapt. Strateg. Glob. Change 2009, 14, 605–625. [Google Scholar] [CrossRef]
- Folch, A.; Planas, J. Cooperation, Fair Trade, and the Development of Organic Coffee Growing in Chiapas (1980–2015). Sustainability 2019, 11, 357. [Google Scholar] [CrossRef]
- Talhinhas, P.; Batista, D.; Diniz, I.; Vieira, A.; Silva, D.N.; Loureiro, A.; Tavares, S.; Pereira, A.P.; Azinheira, H.G.; Guerra-Guimarães, L.; et al. The coffee leaf rust pathogen Hemileia vastatrix: One and a half centuries around the tropics. Mol. Plant Pathol. 2017, 18, 1039–1051. [Google Scholar] [CrossRef] [PubMed]
- Lam-Gutiérrez, A.; Winkler, R.; Garrido-Ramírez, E.R.; Rincón-Rosales, R.; Gutiérrez-Miceli, F.A.; Peña-Ocaña, B.A.; Guzmán-Albores, J.M.; Ruíz-Valdiviezo, V.M. Antifungal activity of root extracts from Baccharis salicina on germination of uredospores of Hemileia vastatrix. Int. J. Agric. Biol. 2021, 25, 1075–1084. [Google Scholar] [CrossRef]
- Ferreira, L.C.; Scavroni, J.; Vaz da Silva, J.R.; Cataneo, A.C.; Martins, D.; Fernandes Boaro, C.S. Copper oxychloride fungicide and its effect on growth and oxidative stress of potato plants. Pestic. Biochem. Physiol. 2014, 112, 63–69. [Google Scholar] [CrossRef] [PubMed]
- Avelino, J.; Cristancho, M.; Georgion, S.; Imbach, P.; Aguilar, L.; Bornemann, G.; Laderach, P.; Anzueto, F.; Hruska, A.J.; Morales, C. The coffee rust crises in Colombia and Central America: Impacts, plausible causes and proposed solutions. Food Sec. 2015, 7, 303–321. [Google Scholar] [CrossRef]
- de Resende, M.L.V.; Pozza, E.A.; Reichel, T.; Botelho, D.M.S. Strategies for Coffee Leaf Rust Management in Organic Crop Systems. Agronomy 2021, 11, 1865. [Google Scholar] [CrossRef]
- Mishra, M.; Srivastava, D. Mycoremediation: A Step towards Sustainability. IJPE 2020, 6, 298–305. Available online: https://ijplantenviro.com/index.php/IJPE/article/view/1312 (accessed on 19 December 2024). [CrossRef]
- Kumar, V.; Dwivedi, S.K. Mycoremediation of heavy metals: Processes, mechanisms, and affecting factors. Environ. Sci. Pollut. Res. 2021, 28, 10375–10412. [Google Scholar] [CrossRef] [PubMed]
- Dusengemungu, l.; Kasali, G.; Gwanama, C.; Ouma, K.O. Recent Advances in Biosorption of Copper and Cobalt by Filamentous Fungi. Front. Microbiol. 2020, 11, 582016. [Google Scholar] [CrossRef] [PubMed]
- Mohamadhasani, F.; Rahimi, M. Growth response and mycoremediation of heavy metals by fungus Pleurotus sp. Sci. Rep. 2022, 12, 19947. [Google Scholar] [CrossRef] [PubMed]
- Robinson, J.R.; Isikhuemhen, O.S.; Anike, F.N. Fungal–Metal Interactions: A Review of Toxicity and Homeostasis. J. Fungi 2021, 7, 225. [Google Scholar] [CrossRef] [PubMed]
- Li, X.; Wang, Y.; Pan, Y.; Yu, H.; Zhang, X.; Shen, Y.; Jiao, S.; Wu, K.; La, G.; Yuan, Y.; et al. Mechanisms of Cd and Cr removal and tolerance by macrofungus Pleurotus ostreatus HAU-2. J. Hazard. Mater. 2017, 330, 1–8. [Google Scholar] [CrossRef] [PubMed]
- Xu, H.; Song, P.; Gu, W.; Yang, Z. Effects of heavy metals on production of thiol compounds and antioxidant enzymes in Agaricus bisporus. Ecotoxicol. Environ. Saf. 2011, 74, 1685–1692. [Google Scholar] [CrossRef]
- Sun, K.; Li, S.; Yu, J.; Gong, R.; Si, Y.; Liu, X.; Chu, G. Cu2+-assisted laccase from Trametes versicolor enhanced self-polyreaction of triclosan. Chemosphere 2019, 225, 745–754. [Google Scholar] [CrossRef]
- Ipeaiyeda, A.R.; Adenipekun, C.O.; Oluwole, O.; Lin, C. Bioremediation potential of Ganoderma lucidum (Curt:Fr) P. Karsten to remove toxic metals from abandoned battery slag dumpsite soil and immobilisation of metal absorbed fungi in bricks. Cogent Environ. Sci. 2020, 6, 1847400. [Google Scholar] [CrossRef]
- Manzano-Gómez, L.A.; Guzmán-Albores, J.M.; Rincón-Rosales, R.; Winkler, R.; Rincón-Molina, C.I.; Castañón-González, J.H.; Ruiz-Lau, N.; Gutiérrez-Miceli, F.A.; Rincón-Molina, F.A.; Ruíz-Valdiviezo, V.M. Evaluation of Metabolomic Profile and Growth of Moringa oleifera L. Cultivated with Vermicompost under Different Soil Types. Agronomy 2021, 11, 2061. [Google Scholar] [CrossRef]
- Rincón-Molina, C.I.; Martinez-Romero, E.; Ruiz-Valdiviezo, V.M.; Velázquez, E.; Ruiz-Lau, N.; Rogel-Hernández, M.A.; Villalobos-Maldonado, J.J.; Rincón-Rosales, R. Plant growth-promoting potential of bacteria associated to pioneer plants from an active volcanic site of Chiapas (Mexico). Appl. Soil Ecol. 2020, 146, 103390. [Google Scholar] [CrossRef]
- Malinowski, R.; Sotek, Z.; Stasinska, M.; Malinowska, K.; Radke, P.; Malinowska, A. Bioaccumulation of Macronutrients in Edible Mushrooms in Various Habitat Conditions of NW Poland—Role in the Human Diet. Int. J. Environ. Res. Public Health 2021, 18, 8881. [Google Scholar] [CrossRef] [PubMed]
- Lodge, D.J.; Ammirati, J.; O’Dell, T.E.; Mueller, G.M. Collecting and describing macrofungi: Inventory and monitoring methods. In Biodiversity of Fungi: Inventory and Monitoring Methods; Mueller, G.M., Bills, G., Foster, M.S., Eds.; Elsevier Academic Press: Amsterdam, The Netherlands, 2004; pp. 128–158. [Google Scholar]
- Franco López, J.; de la Cruz Agüero, G.; Cruz Gómez, A.; Rocha Ramírez, A.; Bedia Sánchez, C.M.; Kato Miranda, E.; Flores Martínez, G.; Abarca Arenas, L.G.; Navarrete Salgado, N.; Sánchez Colón, S. Manual de Ecología, 2nd ed.; Trillas: Mexico City, Mexico, 1989; pp. 1–266. ISBN 968-24-3218-9. [Google Scholar]
- Guzmán, G. Identificación de los Hongos Comestibles, Venenosos, Alucinantes y Destructores de la Madera; Limusa: Mexico City, Mexico, 1977; 435p. [Google Scholar]
- Dellaporta, S.L.; Wood, J.; Hicks, J.B. A plant DNA minipreparation: Version II. Plant Mol. Biol. Rep. 1983, 1, 19–21. [Google Scholar] [CrossRef]
- Wang, X.W.; Jiang, J.H.; Liu, S.L.; Gafforov, Y.; Zhou, L.W. Advances in fungal phylogenomics and their impact on fungal systematics. Phytopathology 2022, 112, 404–413. [Google Scholar] [CrossRef] [PubMed]
- Tamura, K.; Stecher, G.; Peterson, D.; Filipski, A.; Kumar, S. MEGA6: Molecular Evolutionary Genetics Analysis Version 6.0. Mol. Biol. Evol. 2013, 30, 2725–2729. [Google Scholar] [CrossRef] [PubMed]
- Bidaud, A.-L.; Schwarz, P.; Herbreteau, G.; Dannaoui, E. Techniques for the Assessment of In Vitro and In Vivo Antifungal Combinations. J. Fungi 2021, 7, 113. [Google Scholar] [CrossRef] [PubMed]
- Kan, S.H.; Sun, B.Y.; Xu, F.; Song, Q.X.; Zhang, S.F. Biosorption of aquatic copper (II) by mushroom biomass Pleurotus eryngii: Kinetic and isotherm studies. Water Sci. Technol. 2015, 71, 283–288. [Google Scholar] [CrossRef] [PubMed]
- Vrsanska, M.; Voberkova, S.; Langer, V.; Palovcikova, D.; Moulick, A.; Adam, V.; Kopel, P. Induction of Laccase, Lignin Peroxidase and Manganese Peroxidase Activities in White-Rot Fungi Using Copper Complexes. Molecules 2016, 21, 1553. [Google Scholar] [CrossRef]
- Thakur, M. Mushrooms as a Biological Tool in Mycoremediation of Polluted Soils. In Emerging Issues in Ecology and Environmental Science; Springer Briefs in Environmental Science; Springer: Cham, Switzerland, 2019. [Google Scholar] [CrossRef]
- Arif, Y.; Singh, P.; Siddiqui, H.; Bajguz, A.; Hayat, S. Salinity-induced physiological and biochemical changes in plants: An omic approach towards salt stress tolerance. Plant Physiol. Biochem. 2020, 156, 64–77. [Google Scholar] [CrossRef] [PubMed]
- Zhao, Q.; Xiong, W.; Xing, Y.; Shi, X.; Wei, Z. Long-term coffee monoculture alters soil chemical properties and microbial communities. Sci. Rep. 2018, 8, 6116. [Google Scholar] [CrossRef]
- Cotrufo, M.F.; Lavallee, J.M. Soil Organic Matter Formation, Persistence, and Functioning: A Synthesis of Current Understanding to Inform Its Conservation and Regeneration. In Advances in Agronomy; Sparks, D.L., Ed.; Academic Press: Cambridge, MA, USA, 2022; Volume 172, pp. 1–66. [Google Scholar] [CrossRef]
- Krouk, G.; Kiba, T. Nitrogen and Phosphorus interactions in plants: From agronomic to physiological and molecular insights. Curr. Opin. Plant Biol. 2020, 57, 104–109. [Google Scholar] [CrossRef]
- Xie, K.; Cakmak, I.; Wang, S.; Zhang, F.; Guo, S. Synergistic and antagonistic interactions between potassium and magnesium in higher plants. Crop J. 2021, 9, 249–256. [Google Scholar] [CrossRef]
- Gong, Q.; Wang, L.; Dai, T.; Zhou, J.; Kang, Q.; Chen, H.; Li, K.; Li, Z. Effects of copper on the growth, antioxidant enzymes and photosynthesis of spinach seedlings. Ecotoxicol. Environ. Saf. 2019, 171, 771–780. [Google Scholar] [CrossRef] [PubMed]
- Zhang, H.; Zhang, J.; Liu, Y.; Tang, C. Recent Advances in the Preparation, Structure, and Biological Activities of β-Glucan from Ganoderma Species: A Review. Foods 2023, 12, 2975. [Google Scholar] [CrossRef] [PubMed]
- Andlar, M.; Rezić, T.; Marđetko, N.; Kracher, D.; Ludwig, R.; Šantek, B. Lignocellulose degradation: An overview of fungi and fungal enzymes involved in lignocellulose degradation. Eng. Life Sci. 2018, 18, 768–778. [Google Scholar] [CrossRef] [PubMed]
- De Sousa, I.A.L.; Boari, A.J.; Santos, A.S. Ligninolytic enzyme potential of Trametes spp. associated with leaf litter in riparian forest of the Amazônia region. Braz. J. Biol. 2024, 84, e282099. [Google Scholar] [CrossRef] [PubMed]
- Hu, Y.; Bandara, A.R.; Xu, J.; Kakumyan, P.; Hyde, K.D.; Mortimer, P.E. The Use of Agaricus subrufescens for Rehabilitation of Agricultural Soils. Agronomy 2022, 12, 2034. [Google Scholar] [CrossRef]
- Buratti, S.; Rinaldi, F.; Calleri, E.; Bernardi, M.; Oliva, D.; Malgaretti, M.; De Girolamo, G.; Barucco, B.; Girometta, C.E.; Savino, E. Ganoderma resinaceum and Perenniporia fraxinea: Two Promising Wood Decay Fungi for Pharmaceutical Degradation. J. Fungi 2023, 9, 555. [Google Scholar] [CrossRef] [PubMed]
- Levin, L.; Forchiassin, F.; Ramos, A.M. Copper induction of lignin-modifying enzymes in the white-rot fungus Trametes trogii. Mycologia 2002, 94, 377–383. [Google Scholar] [CrossRef]
- Priyanka; Dwivedi, S.K. Fungi mediated detoxification of heavy metals: Insights on mechanisms, influencing factors and recent developments. J. Water Process Eng. 2023, 53, 103800. [Google Scholar] [CrossRef]
- Baldrian, P. Fungal laccases—Occurrence and properties. FEMS Microbiol. Rev. 2006, 30, 215–242. [Google Scholar] [CrossRef]
- Kostadinova, N.; Krumova, E.; Boeva, R.; Abrashev, R.; Miteva-Staleva, J.; Spassova, B.; Angelova, M. Effect of copper ions on the ligninolytic enzyme complex and the antioxidant enzyme activity in the white-rot fungus Trametes trogii 46. Plant Biosyst. 2018, 152, 1128–1133. [Google Scholar] [CrossRef]
- Rau, U.; Kuenz, A.; Wray, V.; Nimtz, M.; Wrenger, J.; Cicek, H. Production and Structural Analysis of the Polysaccharide Secreted by Trametes (Coriolus) versicolor ATCC 200801. Appl. Microbiol. Biotechnol. 2009, 81, 827–837. [Google Scholar] [CrossRef]
- Baldrian, P. Interactions of heavy metals with white-rot fungi. Enzyme Microb. Technol. 2003, 32, 78–91. [Google Scholar] [CrossRef]
- Arantes, V.; Milagres, A.M.F. The synergistic action of ligninolytic enzymes (MnP and laccase) from white-rot fungi for degradation of organic compounds. Enzyme Microb. Technol. 2007, 42, 17–22. [Google Scholar] [CrossRef]
- Jarvinen, J.; Taskila, S.; Isomaki, R.; Ojamo, H. Screening of white-rot fungi manganese peroxidases. AMB Express 2012, 2, 1–9. [Google Scholar] [CrossRef] [PubMed]
Disclaimer/Publisher’s Note: The statements, opinions and data contained in all publications are solely those of the individual author(s) and contributor(s) and not of MDPI and/or the editor(s). MDPI and/or the editor(s) disclaim responsibility for any injury to people or property resulting from any ideas, methods, instructions or products referred to in the content. |
© 2024 by the authors. Licensee MDPI, Basel, Switzerland. This article is an open access article distributed under the terms and conditions of the Creative Commons Attribution (CC BY) license (https://creativecommons.org/licenses/by/4.0/).